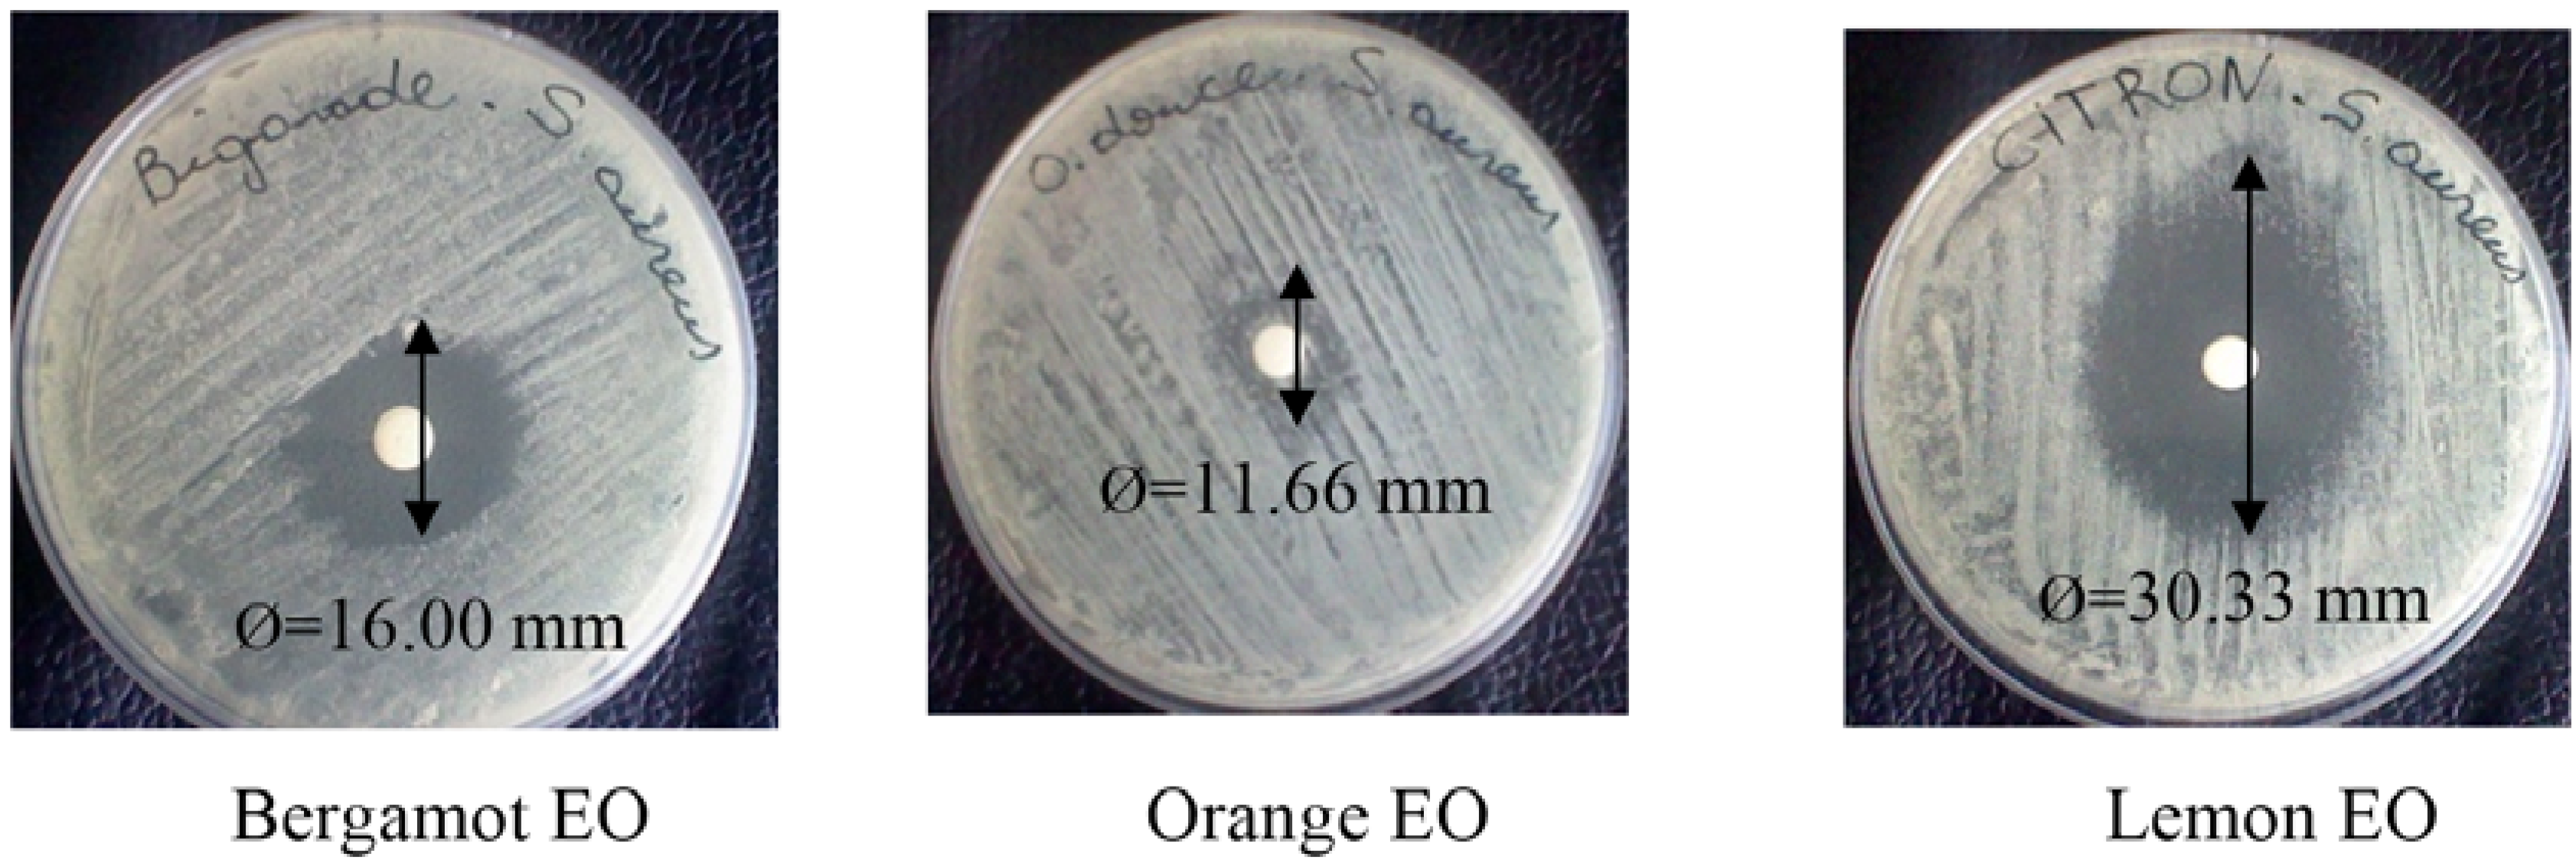
Foods 04 00208 g005 1024

Chemical Profile, Antibacterial and Antioxidant Activity of Algerian Citrus Essential Oils and Their Application in Sardina pilchardus
Abstract
:1. Introduction
2. Results and Discussion
2.1. Yields and Chemical Constituents of Essential Oils
| No. | Compounds *,•,▪ | RI a | Percentage (%) b | ||
|---|---|---|---|---|---|
| Bergamot EO | Lemon EO | Orange EO | |||
| 1 | α-Pinene | 935 | 00.77 | 03.07 | 00.22 |
| 2 | β-Phellandrene | 964 | 01.92 | - | - |
| 3 | β-Pinene | 980 | 03.45 | 17.04 | 01.62 |
| 4 | β-Myrcene | 990 | - | 02.37 | 03.20 |
| 5 | Octanal | 1006 | 01.25 | - | - |
| 6 | Carene | 1020 | - | - | 01.09 |
| 7 | Limonene | 1033 | 77.37 | 51.40 | 02.20 |
| 8 | Ocimene | 1048 | - | - | 02.24 |
| 9 | γ-Terpinene | 1060 | - | 13.46 | - |
| 10 | β-Linalool | 1080 | 01.22 | - | 23.37 |
| 11 | Decanal | 1175 | 00.83 | - | - |
| 12 | Nerol | 1207 | - | 01.50 | - |
| 13 | Geraniol | 1234 | - | 02.43 | - |
| 14 | Linanyle acetate | 1255 | - | - | 37.29 |
| 15 | Citral | 1336 | - | - | 00.34 |
| 16 | Neryl acetate | 1365 | - | 01.05 | 04.10 |
| 17 | Geranyl acetate | 1384 | - | - | 06.35 |
| 18 | Caryophyllene | 1428 | - | - | 01.12 |
| 19 | Naphtalene | - | 01.42 | - | - |
| 20 | Isocaryophyllene | - | - | 01.23 | - |
| Total identified components (%) | 88.21 | 93.55 | 83.14 | ||
| Yields (%) | 0.60 | 0.70 | 0.58 | ||




2.2. Screening of Essential Oils (Disc Assay)
| Ø a (mm) | ||||
|---|---|---|---|---|
| Lemon EO | Bergamot EO | Orange EO | Chloramphenicol | |
| S. aureus CECT 4459 | 30.33 ± 1.53 x | 16.00 ± 1.00 y | 11.66±1.50 z | 21.42 ± 0.90 w |
2.3. Microdilution Assay
| MIC (μL/mL) * | |||
|---|---|---|---|
| Lemon EO | Bergamot EO | Chloramphenicol | |
| S. aureus CECT 4459 | 0.25 | 0.40 | 0.15 |
2.4. Application in Sardine
2.4.1. Antimicrobial Activity


2.4.2. Antioxidant Activity


3. Experimental Section
3.1. Plant Material and Isolation Procedure
3.2. Essential Oil Analysis
3.2.1. Gas Chromatography
3.2.2. Gas Chromatography-Mass Spectrometry
3.2.3. Identification of Components
3.3. Antibacterial Activity
3.3.1. Microorganism
3.3.2. Screening Method
3.3.3. Determination of the Minimum Inhibitory Concentration
3.4. Application in Sardine
3.4.1. Inhibitory Effect of the EOs against S. aureus Inoculated in Sardine
3.4.2. S. aureus Enumeration
3.4.3. Antioxidant Effect of the EOs in Treated Sardine
3.5. Statistical Analysis
4. Conclusions
Acknowledgements
Conflicts of Interest
References
- Bouderoua, K.; Mourot, J.; Benmehdi-Tabet-Aoull, F.; Selselet-Attou, G. The effects of season and site of catch on morphometric characteristics, mineral content, and fatty acids of sardines (Sardina pilchardus) caught on the Algerian coast. J. Aqua. Food Prod. Technol. 2011, 20, 412–420. [Google Scholar] [CrossRef]
- German, J.B.; Kinsella, J.E. Lipid oxidation in fish tissue. Enzymatic initiation via lipoxygenase. J. Agric. Food Chem. 1985, 33, 680–683. [Google Scholar] [CrossRef]
- Hultin, H.O. Oxidation of lipids in seafoods. In Seafoods: Chemistry, Processing Techonolgy and Quality; Blackie Academic & Professional: Glasgow, UK, 1994; pp. 49–74. [Google Scholar]
- Nunes, M.L.; Batista, I.M. Physical, chemical and sensory analysis of sardina (Sardina pilchardus) stored in ice. J. Sci. Food Agric. 1992, 59, 37–43. [Google Scholar] [CrossRef]
- Djenane, D.; Meddahi, A.; Roncalés, P. Les systèmes antioxydants et antimicrobiens pour la conservation de la viande. Sci. Alim. 2006, 26, 37–73. [Google Scholar] [CrossRef]
- Djenane, D.; Yangüela, J.; Roncalés, P. A review and future potential approach for Campylobacter control in retail poultry meats. Afr. J. Microbiol. Res. 2014, 8, 4041–4052. [Google Scholar]
- Fernandez-Lopez, J.; Zhi, N.; Aleson-Carbonell, L.; Perez-Alvarez, J.A.; Kuri, V. Antioxidant and antibacterial activities of natural extracts: Application in beef meatballs. Meat Sci. 2005, 69, 371–380. [Google Scholar] [CrossRef] [PubMed]
- Fisher, K.; Phillips, C. The effect of lemon, orange and bergamot essential oils and their components on the survival of Campylobacter jejuni, Esherichia coli O157: H7, Listeria monocytogenes, Bacillus cereus and Staphylococcus aureus, in vitro and in food systems. J. Appl. Microbiol. 2006, 101, 1232–1240. [Google Scholar] [CrossRef] [PubMed]
- Kotzekidou, P.; Giannakidis, P.; Boulamatsis, A. Antimicrobial activity of some plant extracts and essential oils against food borne pathogens in vitro and on the fate of inoculated pathogens in chocolate. LWT-Food Sci. Technol. 2007, 41, 119–127. [Google Scholar] [CrossRef]
- Caccioni, D.R.L.; Guizzardi, M.; Biondi, D.M.; Agatino, R.; Ruberto, G. Relationship between volatile components of citrus fruit essential oils and antimicrobial action on Penicillium digitatum and Penicillium italicum. Int. J. Food Microbiol. 1998, 43, 73–79. [Google Scholar] [CrossRef]
- Nannapaneni, R.; Chalova, V.I.; Crandall, P.G.; Ricke, S.C.; Johnson, M.G.; O’Bryan, C.A. Campylobacter and Arcobacter species sensitivity to commercial orange oil fractions. Int. J. Food Microbiol. 2009, 129, 43–49. [Google Scholar] [CrossRef] [PubMed]
- Espina, L.; Somolinos, M.; Lorán, S.; Conchello, P.; García, D.; Pagán, R. Chemical composition of commercial citrus fruit essential oils and evaluation of their antimicrobial activity acting alone or in combined processes. Food Control. 2011, 22, 896–902. [Google Scholar] [CrossRef]
- Settanni, L.; Palazzolo, E.; Guarrasi, V.; Aleo, A.; Mammina, C.; Moschetti, G.; Germanà, M.A. Inhibition of foodborne pathogen bacteria by essential oils extracted from citrus fruits cultivated in Sicily. Food Control. 2012, 26, 326–330. [Google Scholar] [CrossRef]
- Boukroufa, M.; Boutekedjiret, C.; Petigny, L.; Rakotomanomana, N.; Chemat, F. Bio-refinery of orange peels waste: A new concept based on integrated green and solvent free extraction processes using ultrasound and microwave techniques to obtain essential oil, polyphenols and pectin. Ultrasonics Sonochem. 2015, 24, 72–79. [Google Scholar] [CrossRef] [PubMed]
- Jeannot, V.; Chahboun, J.; Russell, D.; Baret, P. Quantification and determination of chemical composition of essential oil extracted from natural orange blossom water (Citrus aurantium L. ssp. aurantium). Int. J. Aromath. 2005, 15, 94–97. [Google Scholar] [CrossRef]
- Fisher, K.; Rowe, C.; Phillips, C. The survival of three strains of Acrobacter butzleri in the presence of lemon orange and bergamot essential oils and their components in vitro and food. Lett. Appl. Microbiol. 2007, 44, 495–499. [Google Scholar] [CrossRef] [PubMed]
- Eleni, M.; Antonios, M.; George, K.; Alexios-Leandros, S.; Prokopios, M. High quality bergamot oil from Greece: Chemical analysis using chiral gas chromatography and larvicidal activity against the West Nile virus vector. Molecules 2009, 14, 839–849. [Google Scholar] [CrossRef] [PubMed]
- Kelen, M.; Tepe, B. Chemical composition, antioxydant and antimicrobial proprieties of the essential oils of three Salvia species from Turkish flora. Biores. Technol. 2008, 99, 4096–4104. [Google Scholar] [CrossRef] [PubMed]
- Sarrou, E.; Chatzopoulou, P.; Dimassi-Theriou, K.; Therios, I. Volatile constituents and antioxidant activity of peel, flowers and leaf oils of Citrus aurantium L. Growing in Greece. Molecules 2013, 18, 10639–10647. [Google Scholar] [CrossRef] [PubMed]
- Aazza, S.; Lyoussi, B.; Miguel, M.G. Antioxidant and antiacetylcholinesterase activities of some commercial essential oils and their Major compounds. Molecules 2011, 16, 7672–7690. [Google Scholar] [CrossRef] [PubMed]
- Svoboda, K.; Greenaway, R.I. Lemon scented plants. Int. J. Aromath. 2003, 13, 23–32. [Google Scholar] [CrossRef]
- Moufida, S.; Marzouk, B. Biochemical characterization of blood orange, sweet orange, lemon, bergamot and bitter orange. Phytochem. 2003, 62, 1283–1289. [Google Scholar] [CrossRef]
- Vekiari, S.A.; Protopapadakis, E.F.; Papadopoulou, P.; Papanicolaou, D.; Panou, C.; Vamvakias, M. Composition and seasonal variation of the essential oil from leaves and peel of a lemon variety. J. Agric. Food Chem. 2002, 5, 147–153. [Google Scholar] [CrossRef]
- Gancel, A.L.; Ollitrauet, P.; Froelicher, Y.; Tomi, F.; Jacquemond, C.; Luro, F.; Brillouet, J.M. Leaf volatile compounds of six citrus somatic allotetraploid hybribs originating from various combinations of lime, lemon, citron, sweet orange and grapefruit. J. Agric. Food Chem. 2005, 53, 2224–2230. [Google Scholar] [CrossRef] [PubMed]
- Belletti, N.; Nidagijimana, M.; Sisto, C.; Guerzoni, M.E.; Lanciotti, R.; Gardini, F. Evaluation of the antimicrobial activity of Citrus essences on Saccharomyces cerevisiae. J. Agric. Food Chem. 2004, 52, 6932–6938. [Google Scholar] [CrossRef] [PubMed]
- Rehman, S.U.; Hussein, S.; Nawaz, H.; Mushtaq, A.M.; Murtaza, M.A.; Rizvi, A.J. Inhibitory effect of citrus peel essential oils on the microbial growth of bread. Pak. J. Nutr. 2007, 6, 558–561. [Google Scholar] [CrossRef]
- Sharma, N.; Tripathi, A. Fungitoxicity of Citrus sinensis L. essential oil on post-harvest pathogens. World J. Microbiol. Biotechnol. 2006, 22, 587–593. [Google Scholar] [CrossRef]
- Wolford, R.W.; Kesterson, J.W.; Attaway, J.A. Physicochemical properties of citrus essential oils from Florida. J. Agric. Food Chem. 1971, 19, 1097–1102. [Google Scholar] [CrossRef]
- Shaw, P.E. Review of quantitative analysis of citrus essential oils. J. Agric. Food Chem. 1979, 27, 246–257. [Google Scholar] [CrossRef]
- Boelens, M.H. A critical review on the chemical composition of Citrus oils. Perf. Flav. 1991, 16, 17–34. [Google Scholar]
- Smith, D.C.; Forland, S.; Bachanos, E.; Matejka, M.; Barrett, V. Quantitative analysis of citrus fruits extracts by GC/MS: An undergraduate experiment. Chem. Educ. 2001, 6, 28–31. [Google Scholar] [CrossRef]
- Nogata, Y.; Sakamoto, K.; Shiratsuchi, H.; Ishii, T.; Yano, M.; Ohta, H. Flavonoid composition of fruit tissue of citrus species. Biosci. Biotechnol. Biochem. 2006, 70, 178–192. [Google Scholar] [CrossRef] [PubMed]
- Fuselli, R.; Susana, B.; Garcia, D.L.R.; Martin, J.; Rosalia, F. Chemical composition and antimicrobial activity of citrus essences on honeybee bacterial pathogen Paenibacillus larvae, the causal agent of American foulbrood. World J. Microbiol. Biotechnol. 2008, 24, 2067–2072. [Google Scholar] [CrossRef]
- Senatore, F.; Napolitano, F.; Ozcan, M. Composition and antibacterial activity of essential oil from Crithmum maritimum L. (Apiaceae) growing wild in Turkey. Flav. Frag. J. 2000, 15, 186–189. [Google Scholar] [CrossRef]
- Minh Tu, N.T.; Thank, L.X.; Une, A.; Ukeda, H.; Sawamura, M. Volatile constituents of Vietnamese pummelo, orange, tangerine and lime peel oils. Flav. Frag. J. 2002, 17, 169–174. [Google Scholar] [CrossRef]
- Djenane, D.; Yangüela, J.; Amrouche, T.; Boubrit, S.; Bousaâd, N.; Roncalés, P. Chemical Composition and Antimicrobial Effects of Essential Oils of Eucalyptus globulus, Myrtus communis and Satureja hortensis Against Escherichia coli O157: H7 and Staphylococcus aureus in Minced Beef. Food Sci. Technol. Int. 2011, 17, 505–515. [Google Scholar] [CrossRef] [PubMed]
- Djenane, D.; Aïder, M.; Yangüela, J.; Idir, L.; Gómez, D.; Roncalés, P. Antioxidant and antibacterial effects of Lavandula and Mentha essential oils in minced beef inoculated with E. coli O157: H7 and S. aureus during storage at abuse refrigeration temperature. Meat Sci. 2012, 92, 667–674. [Google Scholar]
- Billerbeck, V.G. Huiles essentielles et bactérie résistantes aux antibiotiques. Phytotérapie 2007, 5, 249–253. [Google Scholar] [CrossRef]
- Akin, M.; Aktumsek, A. Antibacterial activity and composition of the essential oils of Eucalyptus camaldulensis Dehn. and Myrtus communis L. growing in Northern Cyprus. Afr. J. Biotechnol. 2009, 9, 531–535. [Google Scholar]
- Smith-Palmer, A.; Stewart, J.; Fyfe, L. Antimicrobial properties of plant essential oils and essences against five important food-borne pathogens. Lett. Appl. Microbiol. 1998, 26, 118–122. [Google Scholar] [CrossRef] [PubMed]
- Delaquis, P.J.; Stanich, K.; Girard, B.; Mazza, G. Antimicrobial activity of individual and mixed fraction of dill, cilantro, coriander and eucalyptus essential oil. Int. J. Food Microbiol. 2002, 74, 101–109. [Google Scholar] [CrossRef]
- Burt, S.A. Essential oils: Their antibacterial properties and potential applications in foods. Int. J. Food Microbiol. 2004, 94, 223–253. [Google Scholar] [CrossRef] [PubMed]
- Djenane, D.; Yangüela, J.; Gómez, D.; Roncalés, P. Perspectives on the use of essential oils as antimicrobials against Campylobacter jejuni CECT 7572 in retail chicken meats packaged in microaerobic atmospheres. J. Food Safety 2012, 32, 37–47. [Google Scholar] [CrossRef]
- Mitiku, S.B.; Sawamura, M.; Itoh, T.; Ukeda, H. Volatile components of peel cold-pressed oils of two cultivars of sweet orange (Citrus sinensis (L.) Osbeck from Ethiopia. Flav. Frag. J. 2000, 15, 240–244. [Google Scholar] [CrossRef]
- Djenane, D.; Yangüela, J.; Montañés, L.; Djerbal, M.; Roncalés, P. Antimicrobial activity of Pistacia lentiscus and Satureja montana essential oils against Listeria monocytogenes CECT 935 using laboratory media; efficacy and synergistic potential in minced beef. Food Control 2011, 22, 1046–1053. [Google Scholar] [CrossRef]
- Zhang, Z.; Vriesekoop, F.; Yuan, Q.; Liang, H. Effects of nisin on the antimicrobial activity of D-limonene and its nanoemulsion. Food Chem. 2014, 150, 307–312. [Google Scholar] [CrossRef] [PubMed]
- Zahi, M.R.; Liang, H.; Yuan, Q. Improving the antimicrobial activity of D-limonene using a novel organogel-based nanoemulsion. Food Control 2015, 50, 554–559. [Google Scholar] [CrossRef]
- Oussalah, M.; Caillet, S.; Saucier, L.; Lacroix, M. Inhibitory effects of selected plant essential oils on the growth of four pathogenic bacteria: E. coli O157: H7, Salmonella Typhimurium, Staphylococcus aureus et Listeria monocytogenes. Food Control. 2005, 18, 414–420. [Google Scholar]
- Moreira, M.R.; Ponce, A.G.; del Valle, C.E.; Roura, S.I. Inhibitory parameters of essential oils to reduce a foodborne pathogen. LWT-Food Sci. Technol. 2005, 38, 565–570. [Google Scholar] [CrossRef]
- Nezar, A.I.; Kobilinsky, A.; Tholozan, J.L.; Dubois-Brissonnet, F. Combinations at food antimicrobials at low levels to inhibit the growth of Salmonella Typhimurium: A synergistic effect? Food Microbiol. 2005, 22, 391–398. [Google Scholar]
- Kim, J.M.; Marshall, M.R.; Cornell, J.A.; Preston, J.F.; Wei, C.I. Antibacterial activity of carvacrol, citral, and geraniol against Salmonella Thyphimurium on culture medium and on fish cubes. J. Food Sci. 1995, 60, 1364–1374. [Google Scholar] [CrossRef]
- Mejlholm, O.; Dalgaard, P. Antimicrobial effect of essential oils on seafood spoilage microorganism Photobacterium phosphoreum in liquid media and fish priducts. Lett. Appl. Microbiol. 2002, 34, 27–31. [Google Scholar] [CrossRef] [PubMed]
- Tassou, C.C.; Koutsoumanis, F.; Nychas, G.J.E. Inhibition of Salmonella Enteritidis and Staphylococcus aureus in nutrient broth by mint essential oil. Food Res. Int. 2000, 33, 273–280. [Google Scholar] [CrossRef]
- Mahmoud, B.S.M.; Yamazaki, K.; Miyashita, K.; Il-Shik, S.; Dong-Suk, C.; Suzuki, T. Bacterial microflora of carp (Cyprinus carpio) and its shelf-life extension by essential oil compounds. Food Microbiol. 2004, 21, 657–666. [Google Scholar] [CrossRef]
- Lin, Y.-T.; Labbe, R.G.; Shetty, K. Inhibition of Listeria monocytogenes in fish and meat systems using Oregano and Cranberry synergies. Appl. Environ. Microbiol. 2004, 70, 5672–5678. [Google Scholar] [CrossRef] [PubMed]
- Oussalah, M.; Caillet, S.; Saucier, L.; Lacroix, M. Antibacterial effects of selected plant essential oils on the growth of Pseudomonas putida strain isolated from meat. Meat Sci. 2006, 73, 236–244. [Google Scholar] [CrossRef] [PubMed]
- Inouye, S.; Uchida, K.; Maruyama, N.; Yamaguchi, H.; Abe, S. A novel method to estimate the contribution of the vapour activity of essential oils in agar diffusion assay. Jap. J. Med. Mycol. 2006, 47, 91–98. [Google Scholar] [CrossRef]
- Shahidi, F.; Wanasundara, P.K.J.P.D. Phenolic antioxidant. Crit. Food Sci. Nutr. 1992, 32, 67–103. [Google Scholar] [CrossRef] [PubMed]
- Food and Drug Administration. GRAS Notifications, 2005. Available online: http://www.fda.gov. (accessed on 13 December 2005).
- Fisher, K.; Phillips, C. Potential antimicrobial uses of essential oils in food: Is citrus the answer? A review. Tren. Food Sci. Technol. 2008, 19, 156–164. [Google Scholar] [CrossRef]
- Bocco, A.; Cuvelier, M.E.; Richard, H.; Berset, C. Antioxidant Activity and Phenolic Composition of Citrus Peel and Seed Extracts. J. Agric. Food Chem. 1998, 46, 2123–2129. [Google Scholar] [CrossRef]
- Djenane, D.; Sánchez-Escalante, A.; Beltrán, J.A.; Roncalés, P. The shelf-life of beef steaks treated with dL-lactic acid and antioxidants and stored under modified atmospheres. Food Microbiol. 2003, 20, 1–7. [Google Scholar] [CrossRef]
- Viuda-Martos, M.; Ruiz-Navajas, Y.; Fernandez-Lopez, J.; Perez-Alvarez, J.A. Effect of added citrus fibre and spice essential oils on quality characteristics and shelf-life of mortadella. Meat Sci. 2010, 85, 568–576. [Google Scholar] [CrossRef] [PubMed]
- Adams, R.P. Identification of Essential Oil Components by Gas Chromatography/Quadruple Mass Spectroscopy; Allured Publishing Corporation: Carol Stream, IL, USA, 2001. [Google Scholar]
- Djenane, D.; Sánchez-Escalante, A.; Beltrán, J.A.; Roncalés, P. Extension of the retail display life of fresh beef packaged in modified atmosphere by varying lighting conditions. J. Food Sci. 2001, 66, 181–186. [Google Scholar] [CrossRef]
© 2015 by the authors; licensee MDPI, Basel, Switzerland. This article is an open access article distributed under the terms and conditions of the Creative Commons Attribution license (http://creativecommons.org/licenses/by/4.0/).
Share and Cite
Djenane, D. Chemical Profile, Antibacterial and Antioxidant Activity of Algerian Citrus Essential Oils and Their Application in Sardina pilchardus. Foods 2015, 4, 208-228. https://doi.org/10.3390/foods4020208
Djenane D. Chemical Profile, Antibacterial and Antioxidant Activity of Algerian Citrus Essential Oils and Their Application in Sardina pilchardus. Foods. 2015; 4(2):208-228. https://doi.org/10.3390/foods4020208
Chicago/Turabian StyleDjenane, Djamel. 2015. "Chemical Profile, Antibacterial and Antioxidant Activity of Algerian Citrus Essential Oils and Their Application in Sardina pilchardus" Foods 4, no. 2: 208-228. https://doi.org/10.3390/foods4020208
APA StyleDjenane, D. (2015). Chemical Profile, Antibacterial and Antioxidant Activity of Algerian Citrus Essential Oils and Their Application in Sardina pilchardus. Foods, 4(2), 208-228. https://doi.org/10.3390/foods4020208
